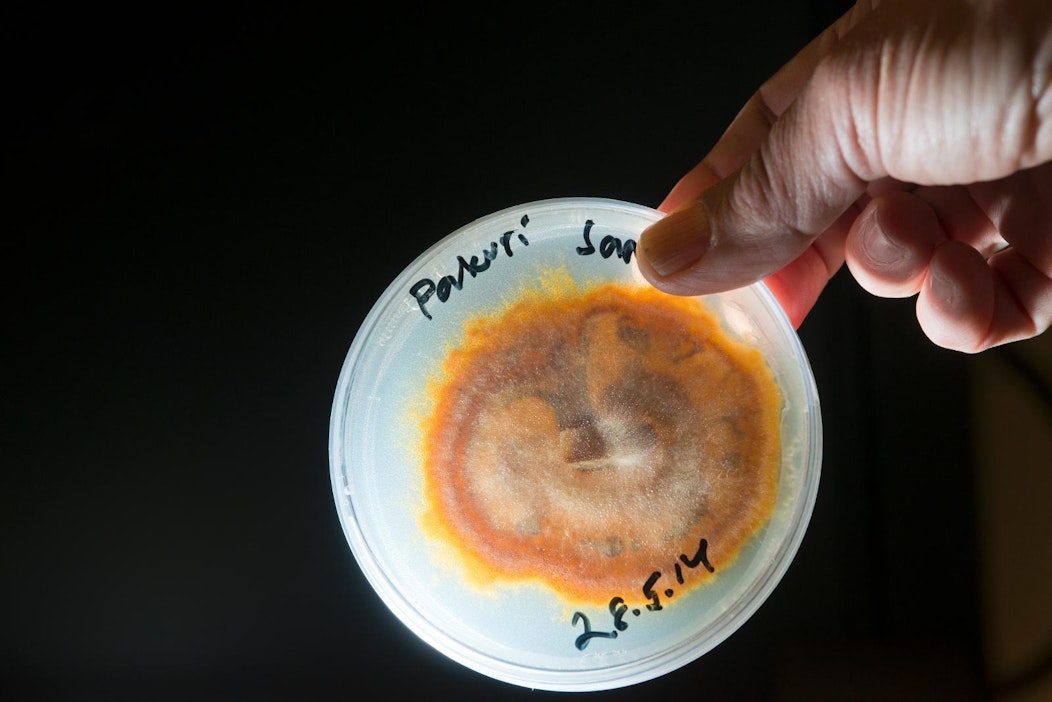

Vihreät kansanedustajat puolustavat Lukea nyt mutta miten oli omalla hallituskaudella?
MT:n mielipidesivuilla on käyty kiivasta keskustelua Luken kehittämisestä. ¨Luonnonvarakeskuksen tutkijat ovat tutkineet esimerkiksi suolla kasvavien mäntyjen sienikasvustoja. Kuva: Aino Saarikivi
¨Luonnonvarakeskuksen tutkijat ovat tutkineet esimerkiksi suolla kasvavien mäntyjen sienikasvustoja. Kuva: Aino SaarikiviVihreiden kansanedustajat Silja Keränen, Hanna Halmeenpää ja Johanna Karimäki moittivat MT:n mielipidesivulla (24.2.2017) hallitusta Luonnonvarakeskus Lukeen kohdistuvista leikkauksista.
"Eihän tässä ole mitään järkeä. Hallitus kaavailee saavansa Suomen nousuun biotaloudella – ja toisella kädellä leikkaa sen tutkimuksesta, kuten kaikesta muustakin tutkimuksesta", kansanedustajat kirjoittajat.
"Tulevaisuuden maailmassa meidän tulee osata tuottaa ruokaamme entistä kestävämmin. Aikamme keskeisimpiä ongelmia ovat ilmastonmuutoksen hillitseminen ja siihen sopeutuminen, maailmanlaajuinen väestönkasvu, ympäristömme kemikalisoituminen. Tutkimukseen tulee panostaa, jotta meillä on tulevaisuudessakin hyvää ruokaa ja elinkelpoinen maapallo."
He korostavat, että tutkijoiden ja tutkimuksen siirtäminen maakunnista ja maaseudulta kaupunkien keskustoihin ja tutkijamäärän rajoittaminen on väärin.
Luken tutkimusylijohtaja Johanna Buchert ja kehitysjohtaja Ilkka P. Laurila korostavat tämän päivän mielipidekirjoituksessaan, että Suomen biotaloustutkimus jatkaa kehittymistään.
"Tutkijoiden osaamisen vahvistamiseksi tutkijaresursseja on keskitetty yliopistokampuksille, jonne näin syntyy vahvempia ja kilpailukykyisempiä osaamiskeskittymiä. Erityisen tärkeää on tutkijoiden ja opiskelijoiden liikkuvuus ja yhteistyö yliopistojen ja tutkimuslaitosten välillä. Tällaiset keskittymät kiinnostavat myös ulkomaisia huippututkijoita", Luken johtajat arvioivat.
"Kampuksilla on tutkimusyhteistyön lisäksi mahdollista rakentaa ja hyödyntää yhteisiä laboratorioita ja tutkimuksen tukipalveluita. Yhteistyö aineiston hankinnassa ja hyödyntämisessä on erityisen tärkeää luonnonvara-alalla."
Heidän mielestään tutkimusympäristöjen kehittäminen vain omiin tarpeisiin on yksinkertaisesti mahdottomuus tilanteessa, jossa myös infran vaatimustaso on kasvussa.
"Se johtaisi infrakustannuksen nousuun ja sitä kautta mittaviin henkilöstövähennyksiin."
Myös Parkanon kaupunginhallituksen puheenjohtaja Ari Lamminmäki pistää mielipidepalstalla lusikkansa Luke-soppaan. Hänen mielestään vihreiden kansanedustajat ovat aivan oikealla asialla, mutta heidän kannanottonsa poikkeaa täysin vihreiden harjoittamasta politiikasta.
"Valmistelu ja päätökset luonnonvaratutkimuslaitosten yhdistämisestä Lukeksi ja sitä kautta toimipaikkojen karsimiseksi ja henkilöstön vähentämiseksi tehtiin Jyrki Kataisen (kok.) hallituksen aikana, missä vihreät olivat mukana päättämässä."
"Kirjoittajien näkemys poikkeaa täysin vihreiden harjoittamasta kaupunki- ja keskittämispolitiikasta, mitä he tekevät erityisesti Helsingissä, Tampereella ja Turussa", Lamminmäki huomauttaa.
"Pirkanmaalaisena olen useissa eri tehtävissä ollut maakunnan ja Parkanon kaupungin toimijoiden kanssa puolustamassa nykyisen Luken, entisen Metsäntutkimuslaitoksen, Parkanon toimipaikan toiminnan jatkumista. Vihreiden edustajia en ole kyllä siinä työssä mukana nähnyt."
Mielipidekirjoitukset kokonaisuudessaan:
Artikkelin aiheetMetsäpalvelu
Miltä metsäsi näyttää euroissa? Katso puun hinta alueittain ja hintojen kehitys koko Suomessa.

- Osaston luetuimmat
